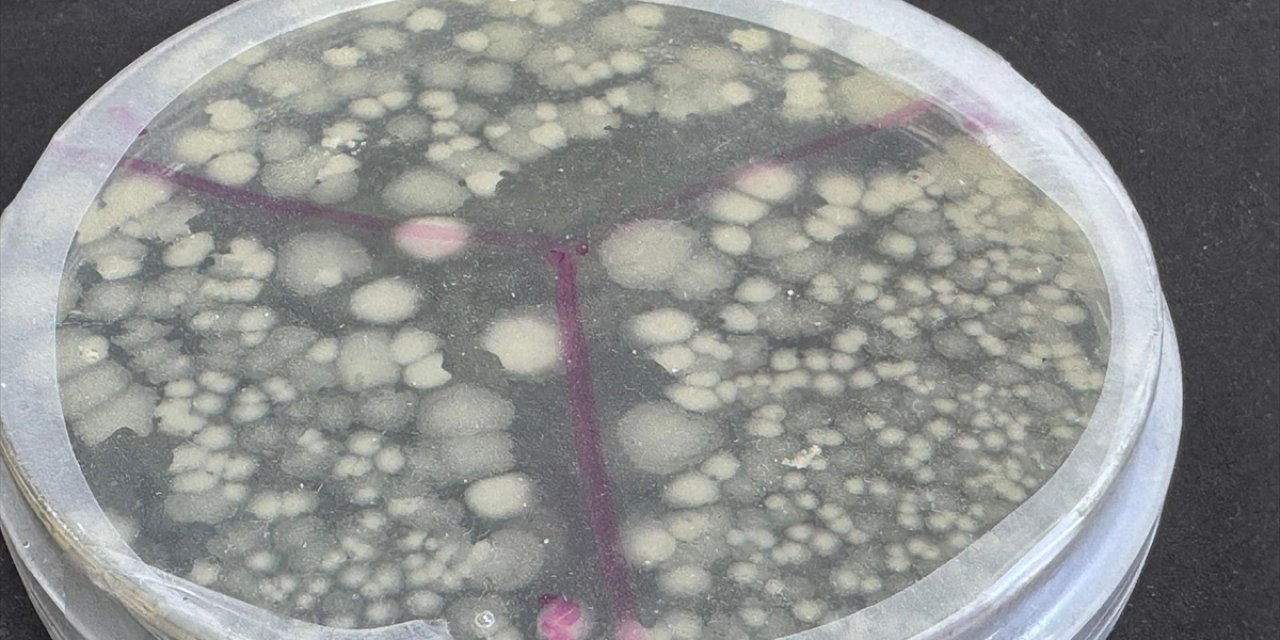
Türkiye'nin İlk Deniz Bakteri İzolatlarını İçeren Mikrobiyal Gübresi Geliştirildi

İstanbul Polisinden "Huzur" Uygulaması
İstanbul'da polis ekipleri, kent genelinde helikopter destekli "huzur" uygulaması yaptı.
Fatih, Beyoğlu ve Kadıköy başta olmak üzere birçok ilçede gerçekleştirilen denetimlere, ilçe emniyet müdürlükleri ile Asayiş ve Trafik Denetleme şube müdürlüklerinden ekipler katıldı.
Uygulama noktalarında durdurulan araçlar detaylı aranırken, sürücü ve yolcuların kimlikleri kontrol edildi.
Taksim Meydanı ve Millet Caddesi’ndeki uygulama noktalarında görevli ekipler, durdurdukları araçların sürücülerinin belgelerini inceledi, yolcuların Genel Bilgi Toplama (GBT) kontrollerini yaptı.
Denetimlere "Bufy" isimli polis köpeği ile helikopter de katıldı.
Muhabir: Yağız Ekrem Çiftçi,Yasin Cingöz
Kaynak:![]()

Türkçe karakter kullanılmayan ve büyük harflerle yazılmış yorumlar onaylanmamaktadır.